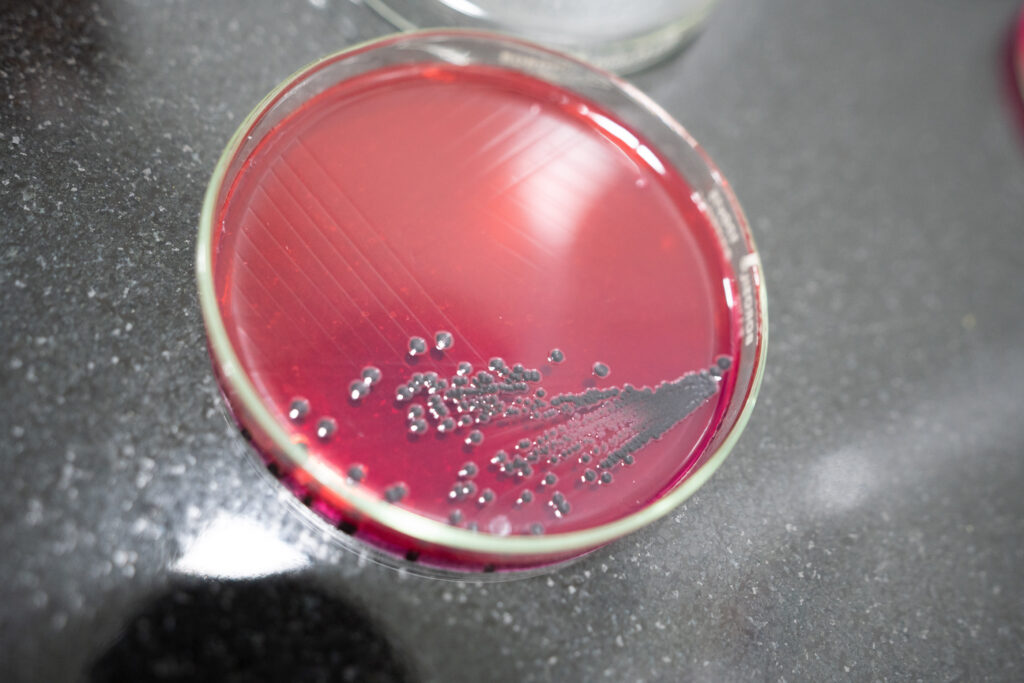
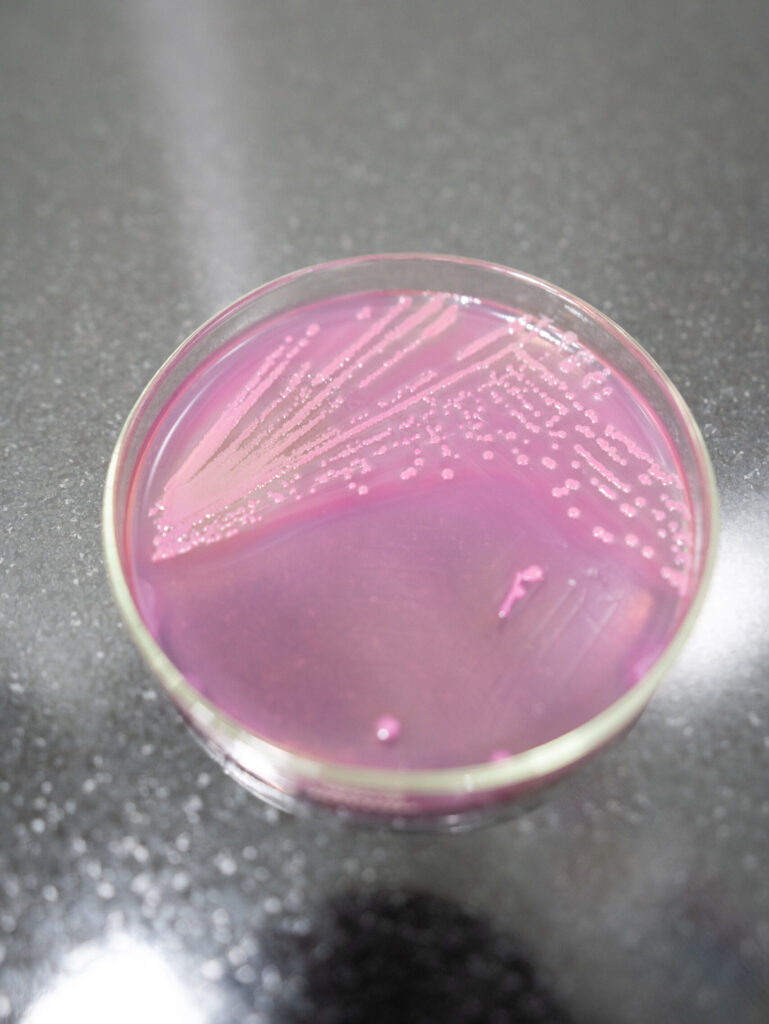
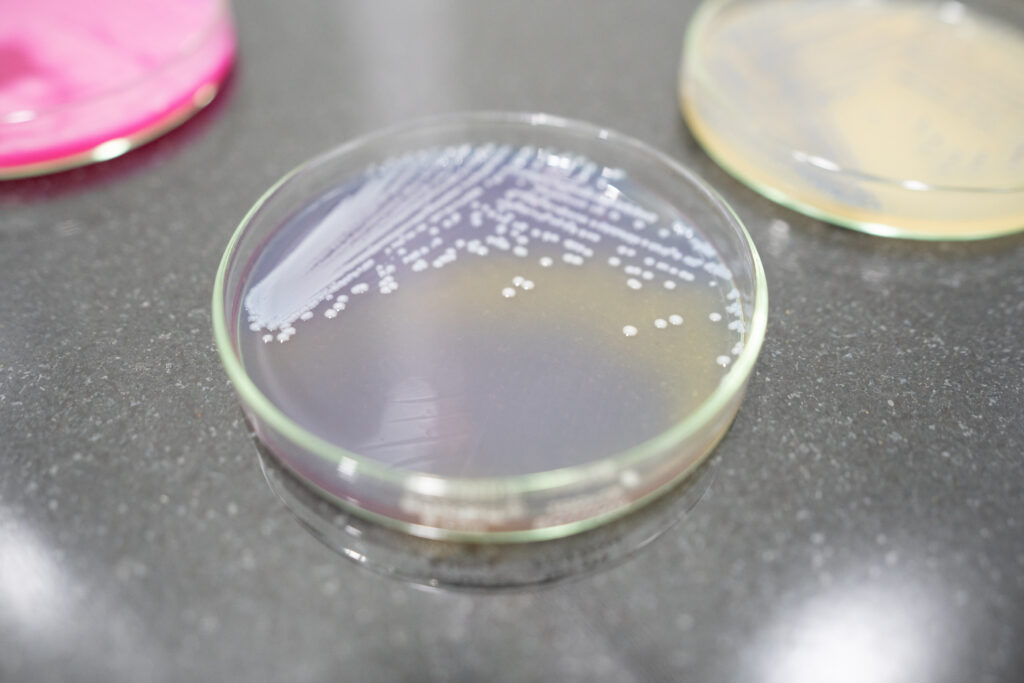
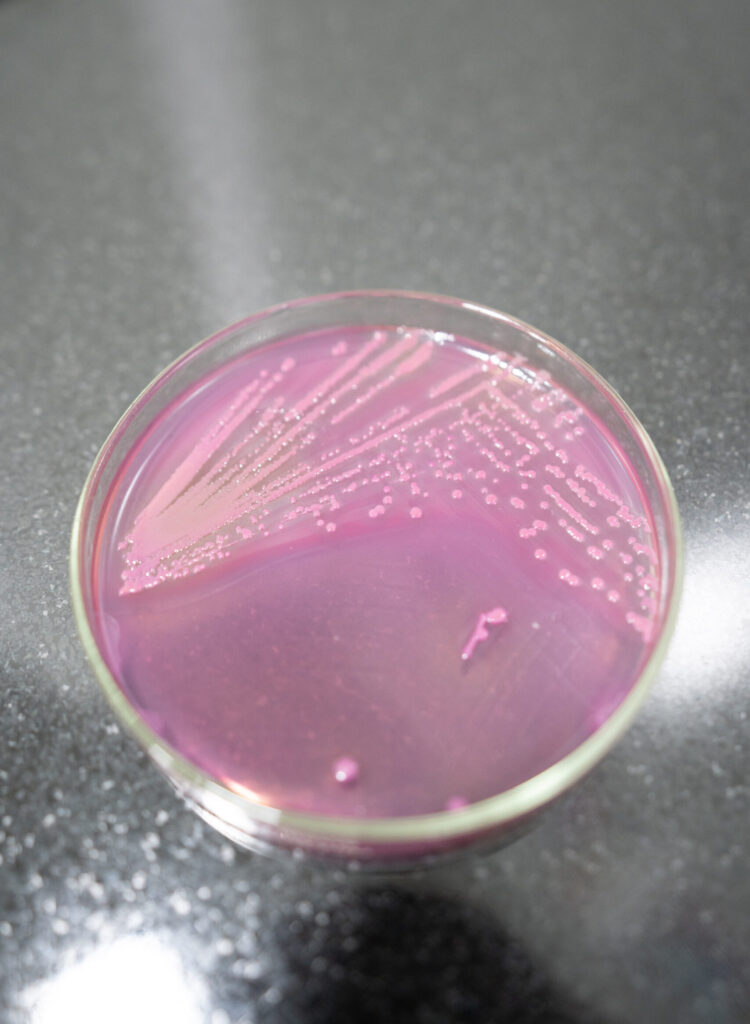

About Us
Our Founders

JAINEET GANDHI
Director and Co-founder
Jaineet Gandhi is a serial entrepreneur and has a rich experience in production technology and quality management. He has served as director at SNG Packing for over 8 years. He’s an MBA from Welingkar’s and has been focused in providing automation techniques and enhancing business competitiveness.

MITESH THAKKER
CEO & Co- Founder
Mitesh Thakker has rich industry experience of 10+ years with Unilever, He has handled various spectrums of business including business strategy, partnerships, product technology development etc. His experience with Fractal Analytics adds up to his technical skills at large. He’s an alumni of VJTI and JBIMS. As a management expert he is also a visiting faculty at JBIMS.

Our infrastructure

VISION
Enabling delivery of quality products everywhere, every time

MISSION
Drive quality management through technological excellence, future proof testing methods and integrated end to end approach

VALUES
•Integrity
•Respect
•Innovation
•Customer & Consumer centricity
Address
J0030, Akshar Business Park, Plot No.03, Sector 25, Vashi, Navi Mumbai - 400703
+91 9136053020
Support Email
support@audenteslabs.com
Enquiry Email
Sales2@audenteslabs.com
Audentes.sales@audenteslabs.com
sales@audenteslabs.com

